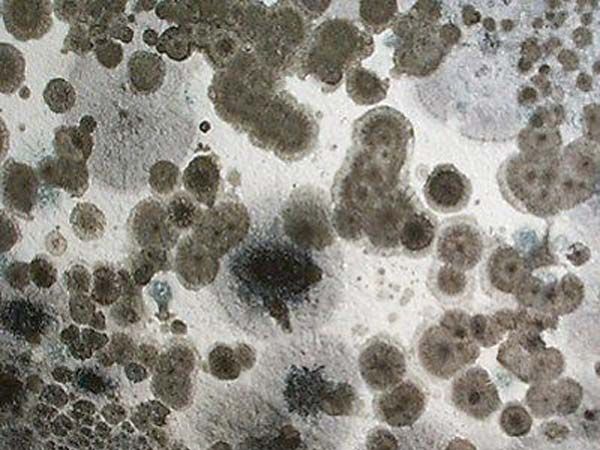

UMIDITÀ AMBIENTALE
L’UMIDITÀ AMBIENTALE NON È PIÙ UN PROBLEMA GRAZIE ALLA VENTILAZIONE MECCANICA CONTROLLATA
Edilbaiardi abile nel trattamento dell’umidità ambientale, ha risposte efficienti nella risoluzione della deumidificazione muraria e della ventilazione meccanica controllata, attraverso soluzioni definitive e all’avanguardia a costi competitivi sul mercato.
Ci occupiamo della vendita e dell’installazione nella tua casa o nel tuo appartamento di impianto di deumidificazione VMC garantendoti:
- ottime prestazione;
- cura del design;
- adattabilità ad ogni stile architettonico;
- basso consumo;
- lunga durata;
- minima manutenzione.
A Mantova e Cremona i nostri sistemi moderni e all’avanguardia sono sempre più richiesti perché consentono:
- un ricambio costante e automatico dell’aria;
- il recupero dell’energia termica;
combattendo in maniera esaustiva l’umidità ambientale.
Mettersi in casa un impianto di deumidificazione VMC significa vivere nel comfort quotidiano di un ambiente salubre con un ricircolo costante d’aria, senza dover aprire di continuo le finestre, evitando inutili dispersioni di calore.
Umidità ambientale e muffa non saranno più un problema con un impianto di deumidificazione VMC. Scegli di fare un investimento mirato, che si ripaga da solo ammortizzando le spese energetiche.
Contatta Edilbaiardi per informazioni e preventivi gratuiti senza impegno.
Siamo attivi su tutte le piazze di Mantova e Cremona.
PERCHÉ SCEGLIERE UN IMPIANTO DI DEUMIDIFICAZIONE VMC
Scegliere un’impianto di deumidificazione VMC significa prediligere il benessere quotidiano attraverso una risposta moderna che permette il ricircolo costante dell’aria in tutti i vani della casa, eliminando:
- batteri e virus;
- fumo di sigaretta;
- umidità ambientale e muffe;
- Co2 prodotto da respirazione e cottura del cibo;
- vapore acqueo prodotto da fumi di bagni e cucine;
- VOC o composti organici volatili prodotti da prodotti di pulizia e arredi;
- odori derivanti da cucina;
- radon che si infiltra da pavimenti e da condotti di passaggio e scarico acqua;
- acari, pollini e particolato.
La loro tecnologia all’avanguardia è a basso consumo energetico e richiede una manutenzione minima.
I sistemi VMC permettono di vivere in un ambiente pulito e soprattutto sano migliorando la classe di efficienza energetica. Facile da installare è perfetto per: bagni, cucine e qualsiasi area.
Contatta Edilbaiardi per informazioni e preventivi gratuiti senza impegno.
Siamo attivi su tutte le piazze di Mantova e Cremona.
EDILBAIARDI VERSATILITÀ E INNOVAZIONE PER RISOLVERE I PROBLEMI DI UMIDITÀ AMBIENTALE
Rivolgendoti a Edilbaiardi puoi disporre di tecnici esperti nella deumidificazione muraria e nella ventilazione meccanica controllata. Specialisti affermati nel campo grazie a tecniche:
- sicure;
- certificate;
- garantite;
- moderne.
Ci distinguiamo per la professionalità, la versatilità e la massima serietà nel distribuire e installare soluzioni innovative, solo dopo aver eseguito un accurato protocollo di diagnosi grazie a sopralluoghi e studi approfonditi.
Il nostro personale vanta una lunga serie di lavori su misura, eseguiti con il massimo della soddisfazione del cliente. Il nostro metodo si basa su un approccio scientifico ecologico, che rappresenta una risposta vincente.
Per avere maggiori informazioni sui nostri modelli contattaci direttamente ai numeri riportati in questo sito, oppure compila l’apposito modulo. Siamo a tua completa disposizione a Mantova, Cremona e limitrofi.
Puoi scegliere tra una vasta gamma di modelli:

ALIANTE
E’ un impianto di deumidificazione VMC, che addolcisce l’aria, l’udito e la vista. Esso, infatti, è dotato di casse acustiche per la diffusione sonora nei vani e di punti luce per una tenue illuminazione. Aliante è un impianto entalpico di ultima generazione, che evita la formazione di condensa e che purifica sia l’aria in entrata che in uscita. Grazie ad un design raffinato è adattabile a qualsiasi contesto architettonico.

ARIAS
Rappresenta una delle ultime novità di VMC e deumidificazione Climapac. Si presenta compatto e minimal per essere installato, con facilità, in qualsiasi contesto. Assicura un ricambio constante dell’aria, eliminando l’umidità in eccesso e evitando la formazione di muffe. Non necessita nessun intervento periodico di sanificazione dei tubi, né trattamenti antimicrobici.

MYBOX
Racchiude due funzioni in un’unica soluzione, scegliendo Mybox, è possibile avere un cassonetto nuovo e isolato e in più un corretto ricambio d’aria. Questo modello assicura la massima efficienza del sistema di ventilazione meccanica controllata, è facile da installare e un design moderno e versatile.

INSIDE
C’è, ma non lo vedi. È un modello innovativo, studiato per i clienti più esigenti. È un Sistema di VMC che ricambia l’aria senza farsi vedere perché scompare all’interno della muratura, restando in vista solo l’interfaccia.
© 2018 Edilbaiardi di Baiardi Giuliano | P.I.02280420205 | Privacy Policy